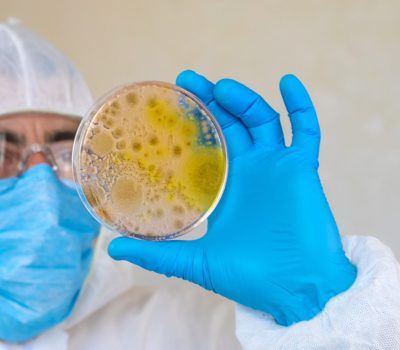
Examine bacteria in petri dishes in the laboratory. Selective focus. nature.

Schimmelgutachter Leverkusen
Schimmelgutachter Leverkusen ist Ihr kompetenter Ansprechpartner, wenn es um die professionelle Begutachtung von Schimmel in Wohn- und Gewerbeobjekten geht. Mit modernster Messtechnik und jahrelanger Erfahrung analysieren wir Ursachen, Ausmaß und Gefahren von Schimmelbefall – zuverlässig, unabhängig und transparent.
Kontakt
Ob Feuchtigkeitsschäden, falsches Lüftungsverhalten oder bauliche Mängel – wir finden die Ursache und erstellen ein detailliertes Gutachten als Grundlage für Sanierungsmaßnahmen oder Versicherungsfälle. Vertrauen Sie auf Schimmelgutachter Leverkusen für eine fachgerechte Schimmelanalyse, rechtssichere Gutachten und nachhaltige Lösungen für ein gesundes Raumklima.
Ihr Profi für Schimmelanalysen, Gutachten und nachhaltigen Lösungen
Meine Leistungen auf einen Blick
Schimmelpilzschäden

Schimmelgutachter Leverkusen bietet unabhängigen, sachlichen und fundierten Sachverstand, um die Ursachen des Schimmelbefalls genau zu bestimmen. Nur durch eine objektive Begutachtung lassen sich effektive Maßnahmen zur Beseitigung und Vorbeugung treffen – ohne unnötige Kosten oder übertriebene Sanierungsmaßnahmen.
Feuchtigkeitsschäden

Mit einer fachgerechten Schadensanalyse ermittelt Schimmelgutachter Leverkusen die tatsächliche Ursache von Feuchtigkeits- oder Schimmelschäden in Ihrem Haus – als Grundlage für eine sichere und dauerhafte Sanierung.

Schimmelgutachter Leverkusen unterstützt Heimwerker und Selbermacher dabei, die Ursachen von Schimmelbefall zuverlässig zu erkennen und richtig einzuschätzen. Durch eine unabhängige und sachliche Analyse erfahren Sie genau, wo das Problem liegt – damit Sie gezielt und kosteneffizient handeln können, ohne unnötige oder übertriebene Sanierungsmaßnahmen durchführen zu müssen.
Schadstoffe

Mit einer fachgerechten Materialanalyse erkennt Asbestgutachter Leverkusen zuverlässig asbesthaltige Baustoffe in Ihrem Gebäude – als Grundlage für eine sichere und vorschriftsmäßige Sanierung.
Bauschäden

Schimmelgutachter Leverkusen erkennt und bewertet Bauschäden, Baumängel und Feuchtigkeitsprobleme in Alt- und Neubauten – als Grundlage für eine sichere und nachhaltige Sanierung.
Kundenreferenzen:
Trustindex überprüft, ob die Originalquelle der Bewertung Google ist. Bausachverständiger Spilker ist ein Baugutachter, wie man sich ihn nur wünschen kann. Vor dem möglichen Erwerb eines sanierungsbedürftigen Einfamilienhauses hat er meine Frau und mich im Rahmen eines Ortstermins hinsichtlich des zu erwartenden Sanierungsaufwandes, der damit verbundenen Kosten und der Höhe des geforderten Kaufpreises ausgezeichnet beraten. Er nahm sich die Zeit, die wir benötigten, um alle Informationen aufzunehmen und die Zusammenhänge zu verstehen. Auch noch nach dem Termin war er telefonisch für uns jederzeit zu sprechen. Vorbildhaft und in jedem Fall eine Empfehlung!Trustindex überprüft, ob die Originalquelle der Bewertung Google ist. Sanierung von Schadstoffen in der Innenwand und Dämmung Herr Spilker hat uns kompetent und zuverlässig beraten, wie wir das bauliche Problem beseitigen können. Mit seiner freundlichen und bodenständigen Art, haben wir uns sehr gut aufgehoben gefühlt. Das Preis-Leistung - Verhältnis war sehr fair. Wir waren rundum zufrieden.Trustindex überprüft, ob die Originalquelle der Bewertung Google ist. Sehr erfahrene und ehrliche ImmobilienbeurteilungenTrustindex überprüft, ob die Originalquelle der Bewertung Google ist. Hervorragende Beratung und außergewöhnlich schnelle Abwicklung Wir haben Herrn Spilker im Rahmen unseres Hauskaufs beauftragt und sind außerordentlich zufrieden. Bereits auf unsere Anfrage am Samstag erhielten wir noch am selben Tag ein erstes Beratungsgespräch, und der Ortstermin konnte schon am darauffolgenden Dienstag stattfinden – eine beeindruckend schnelle und unkomplizierte Abwicklung. Die Beratung war fachlich fundiert, klar verständlich und sehr hilfreich für unsere Entscheidungsfindung. Herr Spilker hat uns mit seiner Expertise und seiner praxisnahen Einschätzung maßgeblich unterstützt. Besonders hervorheben möchten wir die Verlässlichkeit, die hohe Fachkompetenz und die unkomplizierte Kommunikation. Wir können Herrn Spilker uneingeschränkt weiterempfehlen und bedanken uns herzlich für die hervorragende Zusammenarbeit.Trustindex überprüft, ob die Originalquelle der Bewertung Google ist. Herr Spilker hat für uns kurzfristig ein Baugutachten in Essen erstellt. Der Termin wurde schnell organisiert, und er war pünktlich vor Ort. Besonders positiv hervorzuheben ist, dass er sich die Zeit genommen hat, uns alle Inhalte des Gutachtens verständlich zu erklären und uns kompetent zu beraten. Wir fühlten uns sehr gut aufgehoben und würden Herrn Spilker jederzeit weiterempfehlen.Trustindex überprüft, ob die Originalquelle der Bewertung Google ist. Wir brauchten kurzfristig ein Gutachten für ein Haus, das wir kaufen wollten. Herr Spilker hatte spontan Zeit und hat sich richtig viel Mühe gegeben. Er hat das Haus gründlich unter die Lupe genommen und uns danach ausführlich beraten. Genau so stellt man sich das vor: professionell, aber trotzdem persönlich. Klare Empfehlung!Trustindex überprüft, ob die Originalquelle der Bewertung Google ist. Wir hatten Herr Spilker vor dem Kauf unserer Immobilie zur Begutachtung hinzugezogen. Der Termin war innerhalb einer Woche und das Gutachten auch innerhalb eines Tages fertig. Wir haben uns sehr gut und ehrlich beraten gefühlt, Herrn Spilker ist zuverlässig, freundlich und sehr kompetent.Trustindex überprüft, ob die Originalquelle der Bewertung Google ist. Herr Spilker hat uns bereits bei mehreren Immobilien beraten, die wir auf der Suche nach einem Eigenheim besichtigt haben. Jedes einzelne seiner Gutachten war absolut tadellos und hat uns vor bösen Überraschung bewahrt, die einem gegebenenfalls erst nach dem Kauf auffallen und für Mehrkosten intensiven, nicht einkalkulierten Mehraufwand sorgen. Sein Auftreten war dabei zu jederzeit sehr professionell und zuvorkommend. Auch kurzfristige Termine auf Zuruf waren nie ein Problem. Definitiv meine Empfehlung für einen sachverständigen und Baugutachter.Trustindex überprüft, ob die Originalquelle der Bewertung Google ist. Sehr versierter und erfahrener Baugutachter. Wir haben uns zum Kauf unseres Einfamilienhauses perfekt beraten gefühlt. Ich kann nur jedem empfehlen Herrn Spilker bei einem Hauskauf zu kontaktieren. Das Geld das wir investiert haben, haben wir durch die Einsparung beim Kaufpreis mehrfach wettgemacht. Vielen Dank!Verifiziert von: TrustindexDas verifizierte Trustindex-Abzeichen ist das universelle Symbol des Vertrauens. Nur die besten Unternehmen können das verifizierte Abzeichen erhalten, die eine Bewertungsnote über 4.5 haben, basierend auf Kundenbewertungen der letzten 12 Monate. Mehr erfahren
Unverbindliches Angebot anfordern

- +49 (0) 202-69757575
- +49 (0) 176 56849754
- info@schimmelgutachter-spilker.de
Sie haben Fragen, benötigen unterstützung bei Schimmel, bei einem Wasserschaden oder der Bauwerksabdichtung? Wir helfen Ihnen gerne und kümmern uns um Ihr Anliegen.
